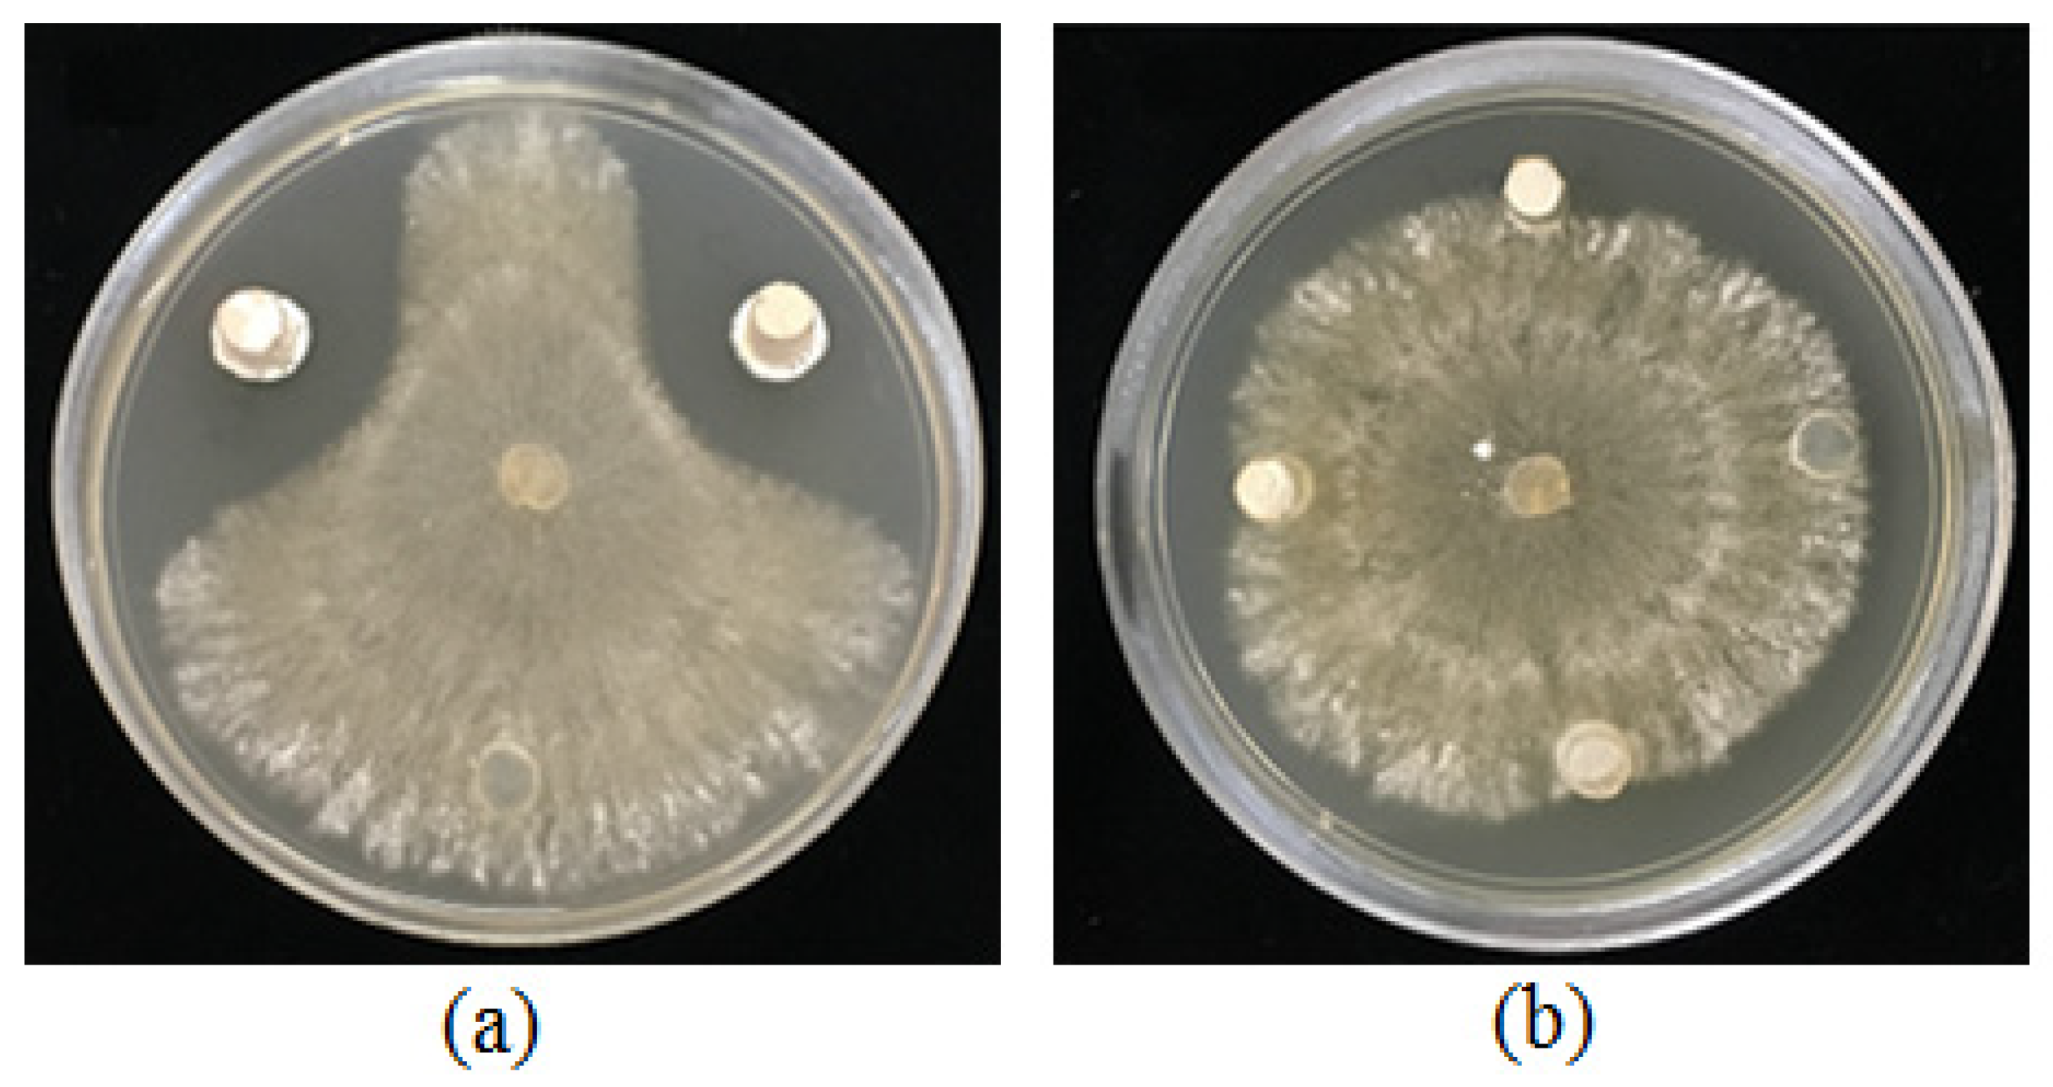
Agronomy 11 01384 g001
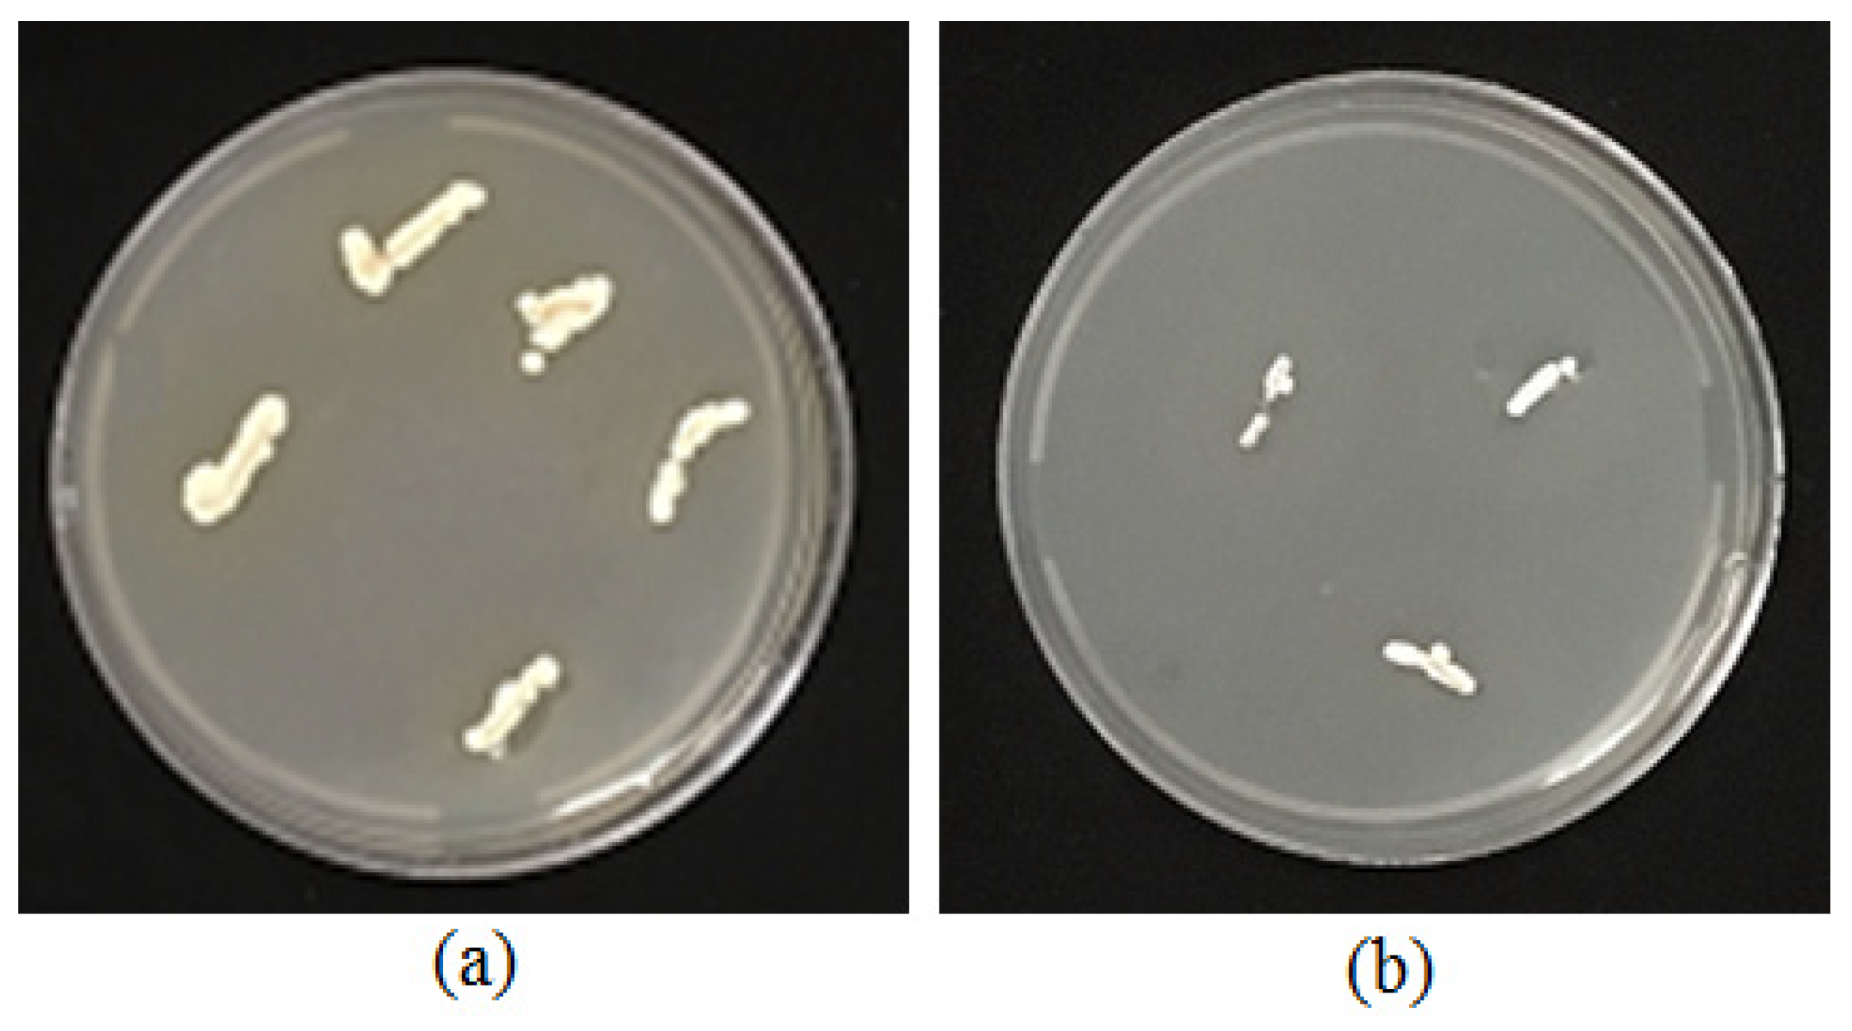
Agronomy 11 01384 g005

Exploring Two Streptomyces Species to Control Rhizoctonia solani in Tomato
Abstract
1. Introduction
2. Materials and Methods
2.1. Culture Media and Preparation of Pathogen
2.2. Sample Collection and Isolation of Actinomycetes
2.3. In Vitro Bioassays
2.4. Siderophore Production
- Ar: Absorbance of reference (CAS solution and un-inoculated broth).
- As: Absorbance of sample (CAS solution and cell free supernatant of sample).
2.4.1. Detection of Catechol and Hydroxamate Type Siderophore
Solvent Extraction of Siderophore
Thin Layer Chromatography (TLC)
2.5. Biochemical Characterization of Selected Actinomycetes Isolates
2.6. Molecular Identification of Actinobacteria
2.7. Root Colonization Test
2.8. Greenhouse Experiments
2.9. RNA Extraction and qPCR Analysis of the Defense Related Genes
2.10. Statistical Analysis
3. Results
3.1. In Vitro Antagonistic Bioassays
3.2. Siderophore Production
3.3. Biochemical Characterization of Selected Actinomycetes Isolates
3.4. Molecular Identification of the Two Active Isolates
3.5. Root Colonization
3.6. Greenhouse Experiments
3.7. Effect of Streptomyces Globisporus and S. praecox on Defense Related Genes Expression
4. Discussion
5. Conclusions
Author Contributions
Funding
Institutional Review Board Statement
Informed Consent Statement
Data Availability Statement
Acknowledgments
Conflicts of Interest
References
- Van der Ent, S.; Van Wees, S.C.M.; Pieterse, C.M.J. Jasmonate signaling in plant interactions with resistance-inducing beneficial microbes. Phytochemistry 2009, 70, 1581–1588. [Google Scholar] [CrossRef] [PubMed]
- Conrath, U. Molecular aspects of defence priming. Trends Plant Sci. 2011, 16, 524–531. [Google Scholar] [CrossRef]
- Conrath, U.; Beckers, G.J.; Flors, V.; García-Agustín, P.; Jakab, G.; Mauch, F.; Newman, M.A.; Pieterse, C.M.; Poinssot, B.; Pozo, M.J.; et al. Priming: Getting ready for battle. Mol. Plant Microbe Interact. 2006, 19, 1062–1071. [Google Scholar] [CrossRef]
- Pieterse, C.M.; Leon-Reyes, A.; Van der Ent, S.; Van Wees, S.C. Networking by small-molecule hormones in plant immunity. Nat. Chem. Boil. 2009, 5, 308–316. [Google Scholar] [CrossRef] [PubMed]
- Mauch-Mani, B.; Baccelli, I.; Luna Diez, E.; Flors, V. Defense priming: An adaptive Part of induced resistance. Annu. Rev. Plant Biol. 2017, 68, 485–512. [Google Scholar] [CrossRef] [PubMed]
- Worrall, D.; Holroyd, G.H.; Moore, J.P.; Glowacz, M.; Croft, P.; Taylor, J.E.; Paul, N.D.; Roberts, M.R. Treating seeds with activators of plant defence generates long-lasting priming of resistance to pests and pathogens. New Phytol. 2012, 193, 770–778. [Google Scholar] [CrossRef] [PubMed]
- Luna, E.; Bruce, T.J.; Roberts, M.R.; Flors, V.; Ton, J. Next-generation systemic acquired resistance. Plant Physiol. 2012, 158, 844–853. [Google Scholar] [CrossRef]
- Slaughter, A.; Daniel, X.; Flors, V.; Luna, E.; Hohn, B.; Mauch-Mani, B. Descendants of primed arabidopsis plants exhibit resistance to biotic stress. Plant Physiol. 2012, 158, 835. [Google Scholar] [CrossRef] [PubMed]
- Van Hulten, M.; Pelser, M.; van Loon, L.C.; Pieterse, C.M.; Ton, J. Costs and benefits of priming for defense in Arabidopsis. Proc. Natl. Acad. Sci. USA 2006, 103, 5602–5607. [Google Scholar] [CrossRef]
- Walters, D.R.; Ratsep, J.; Havis, N.D. Controlling crop diseases using induced resistance: Challenges for the future. J. Exp. Bot. 2013, 64, 1263–1280. [Google Scholar] [CrossRef]
- Ait Barka, E.; Vatsa, P.; Sanchez, L.; Gaveau-Vaillant, N.; Jacquard, C.; Meier-Kolthoff, J.P.; Klenk, H.P.; Clément, C.; Ouhdouch, Y.; van Wezel, G.P. Taxonomy, physiology, and natural products of actinobacteria. Microbiol. Mol. Biol. Rev. 2016, 80, 1–43. [Google Scholar] [CrossRef]
- Bulgarelli, D.; Schlaeppi, K.; Spaepen, S.; van Themaat, E.V.L.; Schulze-Lefert, P. Structure and functions of the bacterial microbiota of plants. Annu. Rev. Plant Biol. 2013, 64, 807–838. [Google Scholar] [CrossRef]
- El-Tarabily, K.A.; AlKhajeh, A.S.; Ayyash, M.M.; Alnuaimi, L.H.; Sham, A.; ElBaghdady, K.Z.; Tariq, S.; AbuQamar, S.F. Growth promotion of Salicornia bigelovii by Micromonospora chalcea UAE1, an endophytic 1-aminocyclopropane-1-carboxylic acid deaminase-producing actinobacterial isolate. Front. Microbiol. 2019, 10, 1694. [Google Scholar] [CrossRef] [PubMed]
- El-Tarabily, K.A.; ElBaghdady, K.Z.; AlKhajeh, A.S.; Ayyash, M.M.; Aljneibi, R.S.; El-Keblawy, A.; AbuQamar, S.F. Polyamine-producing actinobacteria enhance biomass production and seed yield in Salicornia bigelovii. Biol. Fertil. Soils 2020, 56, 499–519. [Google Scholar] [CrossRef]
- Zhang, D.; Lu, Y.; Chen, H.; Wu, C.; Zhang, H.; Chen, L.; Chen, X. Antifungal peptides produced by actinomycetes and their biological activities against plant diseases. J. Antibiot. 2020, 73, 265–282. [Google Scholar] [CrossRef]
- Mathew, B.T.; Torky, Y.; Amin, A.; Mourad, A.-H.I.; Ayyash, M.M.; El-Keblawy, A.; Hilal-Alnaqbi, A.; AbuQamar, S.F.; El-Tarabily, K.A. Halotolerant marine rhizosphere-competent actinobacteria promote Salicornia bigelovii growth and seed production using seawater irrigation. Front. Microbiol. 2020, 11, 552. [Google Scholar] [CrossRef] [PubMed]
- Saeed, E.E.; Sham, A.; Salmin, Z.; Abdelmowla, Y.; Iratni, R.; El-Tarabily, K.; AbuQamar, S. Streptomyces globosus UAE1, a potential effective biocontrol agent for black scorch disease in date palm plantations. Front. Microbiol. 2017, 8, 1455. [Google Scholar] [CrossRef] [PubMed]
- Song, L.; Jiang, N.; Wei, S.; Lan, Z.; Pan, L. Isolation, screening, and identification of actinomycetes with antifungal and enzyme activity assays against Colletotrichum dematium of Sarcandra glabra. Mycobiology 2020, 48, 37–43. [Google Scholar] [CrossRef]
- Patil, H.J.; Srivastava, A.K.; Singh, D.P.; Chaudhari, B.L.; Arora, D.K. Actinomycetes mediated biochemical responses in tomato (Solanum lycopersicum) enhances bioprotection against Rhizoctonia solani. Crop Prot. 2011, 30, 1269–1273. [Google Scholar] [CrossRef]
- Singh, S.; Gupta, R.; Gaur, R.; Srivastava, A. Antagonistic actinomycetes mediated resistance in Solanum lycopersicon Mill. against Rhizoctonia solani Kühn. Proc. Natl. Acad. Sci. India Sect. B Biol. Sci. 2015, 87, 789–798. [Google Scholar] [CrossRef]
- Kurth, F.; Mailänder, S.; Bönn, M.; Feldhahn, L.; Herrmann, S.; Große, I.; Buscot, F.; Schrey, S.D.; Tarkka, M.T. Streptomyces-induced resistance against oak powdery mildew involves host plant responses in defense, photosynthesis, and secondary metabolism pathways. Mol. Plant Microbe Interact. 2014, 27, 891–900. [Google Scholar] [CrossRef] [PubMed]
- Martínez-Hidalgo, P.; García, J.M.; Pozo, M.J. Induced systemic resistance against Botrytis cinerea by Micromonospora strains isolated from root nodules. Front. Microbiol. 2015, 6, 922. [Google Scholar] [CrossRef]
- Jogaiah, S.; Kurjogi, M.; Govind, S.R.; Huntrike, S.S.; Basappa, V.A.; Tran, L.-S.P. Isolation and evaluation of proteolytic actinomycete isolates as novel inducers of pearl millet downy mildew disease protection. Sci. Rep. 2016, 6, 30789. [Google Scholar] [CrossRef]
- Singh, S.P.; Gaur, R. Endophytic Streptomyces spp. underscore induction of defense regulatory genes and confers resistance against Sclerotium rolfsii in chickpea. Biol. Control 2017, 104, 44–56. [Google Scholar] [CrossRef]
- Abbasi, S.; Safaie, N.; Sadeghi, A.; Shamsbakhsh, M. Streptomyces strains induce resistance to Fusarium oxysporum f. sp. lycopersici Race 3 in tomato through different molecular mechanisms. Front. Microbiol. 2019, 10, 1505. [Google Scholar]
- Saikia, K.; Bora, L.C. Exploring actinomycetes and endophytes of rice ecosystem for induction of disease resistance against bacterial blight of rice. Eur. J. Plant Pathol. 2021, 159, 67–79. [Google Scholar] [CrossRef]
- Solanki, M.K.; Robert, A.S.; Singh, R.K.; Kumar, S.; Pandey, A.K.; Srivastava, A.K.; Arora, D.K. Characterization of mycolytic enzymes of Bacillus strains and their bio-protection role against Rhizoctonia solani in tomato. Curr. Microbiol. 2012, 65, 330–336. [Google Scholar] [CrossRef]
- Taheri, P.; Tarighi, S. The role of pathogenesis-related proteins in the tomato-Rhizoctonia solani interaction. J. Bot. 2012, 2012. [Google Scholar] [CrossRef]
- Duniway, J. Status of chemical alternatives to methyl bromide for pre-plant fumigation of soil. Phytopathology 2003, 92, 1337–1343. [Google Scholar] [CrossRef] [PubMed]
- Goudjal, Y.; Toumatia, O.; Yekkour, A.; Sabaou, N.; Mathieu, F.; Zitouni, A. Biocontrol of Rhizoctonia solani damping-off and promotion of tomato plant growth by endophytic actinomycetes isolated from native plants of Algerian Sahara. Microbiol. Res. 2014, 169, 59–65. [Google Scholar] [CrossRef]
- De Curtis, F.; Lima, G.; Vitullo, D.; De Cicco, V. Biocontrol of Rhizoctonia solani and Sclerotium rolfsii on tomato by delivering antagonistic bacteria through a drip irrigation system. Crop Prot. 2010, 29, 663–670. [Google Scholar] [CrossRef]
- Berta, G.; Sampo, S.; Gamalero, E.; Massa, N.; Lemanceau, P. Suppression of Rhizoctonia root-rot of tomato by Glomus mossae BEG12 and Pseudomonas fluorescens A6RI is associated with their effect on the pathogen growth and on the root morphogenesis. Eur. J. Plant Pathol. 2005, 111, 279–288. [Google Scholar] [CrossRef]
- Montealegre, J.; Valderrama, L.; Sánchez, S.; Herrera, R.; Besoain, X.; Perez, L. Biological control of Rhizoctonia solani in tomatoes with Trichoderma harzianum mutants. Electron. J. Biotechnol. 2010, 13, 717–3458. [Google Scholar] [CrossRef][Green Version]
- Manganiello, G.; Sacco, A.; Ercolano, M.R.; Vinale, F.; Lanzuise, S.; Pascale, A.; Napolitano, M.; Lombardi, N.; Lorito, M.; Woo, S.L. Modulation of tomato response to Rhizoctonia solani by Trichoderma harzianum and its secondary metabolite harzianic acid. Front. Microbiol. 2018, 9, 1966. [Google Scholar] [CrossRef]
- Ouhaibi-Ben Abdeljalil, N.; Vallance, J.; Gerbore, J.; Yacoub, A.; Daami-Remadi, M.; Rey, P. Combining potential oomycete and bacterial biocontrol agents as a tool to fight tomato Rhizoctonia root rot. Biol. Control. 2021, 155, 104521. [Google Scholar] [CrossRef]
- KÜSter, E.; Williams, S.T. Selection of media for isolation of Streptomycetes. Nature 1964, 202, 928–929. [Google Scholar] [CrossRef]
- Shahidi Bonjar, G.H.; Fooladi, M.H.; Mahdavi, M.J.; Shahghasi, A. Broadspectrim, a novel antibacterial from Streptomyces sp. Biotechnology 2004, 3, 126–130. [Google Scholar]
- Lee, J.Y.; Hwang, B.K. Diversity of antifungal actinomycetes in various vegetative soils of Korea. Can. J. Microbiol. 2002, 48, 407–417. [Google Scholar] [CrossRef] [PubMed]
- El-Tarabily, K.; Soliman, M.; Nassar, A.H.; Al-Hassani, D.; Sivasithamparam, K.; McKenna, F.; Hardy, G. Biological control of Sclerotinia minor using a chitinolytic bacterium and actinomycetes. Plant Pathol. 2000, 49, 573–583. [Google Scholar] [CrossRef]
- Schwyn, B.; Neilands, J.B. Universal chemical assay for the detection and determination of siderophores. Anal. Biochem. 1987, 160, 47–56. [Google Scholar] [CrossRef]
- Hu, Q.-P.; Xu, J.G. A simple double-layered chrome azurol S agar (SD-CASA) plate assay to optimize the production of siderophores by a potential biocontrol agent Bacillus. Afr. J. Microbiol. Res. 2011, 5, 4321–4327. [Google Scholar]
- Payne, S.M. Iron acquisition in microbial pathogenesis. Trends Microbiol. 1993, 1, 66–69. [Google Scholar] [CrossRef]
- Lee, J.; Postmaster, A.; Soon, H.P.; Keast, D.; Carson, K.C. Siderophore production by actinomycetes isolates from two soil sites in Western Australia. Biometals 2012, 25, 285–296. [Google Scholar] [CrossRef]
- Patel, A.K.; Deshattiwar, M.K.; Chaudhari, B.L.; Chincholkar, S.B. Production, purification and chemical characterization of the catecholate siderophore from potent probiotic strains of Bacillus spp. Bioresour. Technol. 2009, 100, 368–373. [Google Scholar] [CrossRef] [PubMed]
- Memon, B. Detection of siderophores by thin layer chromatography. J. Chem. Soc. Pak. 2005, 27, 658–661. [Google Scholar]
- Mehrotra, S.; Pandey, P.K.; Gaur, R.; Darmwal, N.S. The production of alkaline protease by a Bacillus species isolate. Bioresour. Technol. 1999, 67, 201–203. [Google Scholar] [CrossRef]
- Hsu, S.C.; Lockwood, J.L. Powdered chitin agar as a selective medium for enumeration of actinomycetes in water and soil. Appl. Microbiol. 1975, 29, 422–426. [Google Scholar] [CrossRef] [PubMed]
- Amoozegar, M.A.; Malekzadeh, F.; Malik, K.A. Production of amylase by newly isolated moderate halophile, Halobacillus sp. strain MA-2. J. Microbiol. Methods 2003, 52, 353–359. [Google Scholar] [CrossRef]
- Fernando, W.G.D.; Ramarathnam, R.; Krishnamoorthy, A.S.; Savchuk, S.C. Identification and use of potential bacterial organic antifungal volatiles in biocontrol. Soil Biol. Biochem. 2005, 37, 955–964. [Google Scholar] [CrossRef]
- Tresner, H.D.; Hayes, J.A.; Backus, E.J. Differential tolerance of Streptomycetes to sodium chloride as a taxonomic aid. Appl. Microbiol. 1968, 16, 1134–1136. [Google Scholar] [CrossRef]
- Alström, S.; Burns, R.G. Cyanide production by rhizobacteria as a possible mechanism of plant growth inhibition. Biol. Fert. Soils 1989, 7, 232–238. [Google Scholar] [CrossRef]
- Atashpaz, S.; Khani, S.; Barzegari, A.; Barar, J.; Zununi Vahed, S.; Azarbaijani, R.; Omidi, Y. A robust universal method for extraction of genomic DNA from bacterial species. Mikrobiologiia 2010, 79, 562–566. [Google Scholar] [CrossRef] [PubMed]
- Lane, D.J.; Pace, B.; Olsen, G.J.; Stahl, D.A.; Sogin, M.L.; Pace, N.R. Rapid determination of 16S ribosomal RNA sequences for phylogenetic analyses. Proc. Natl. Acad. Sci. USA 1985, 82, 6955–6959. [Google Scholar] [CrossRef]
- Torabi, A.; Shahidi Bonjar, G.H.; Abdolshahi, R.; Pournamdari, M.; Saadoun, I.; Barka, E.A. Biological control of Paecilomyces formosus, the causal agent of dieback and canker diseases of pistachio by two strains of Streptomyces misionensis. Biol. Control 2019, 137, 104029. [Google Scholar] [CrossRef]
- Zhang, X.-Y.; Yu, X.-X.; Yu, Z.; Xue, Y.-F.; Qi, L.-P. A simple method based on laboratory inoculum and field inoculum for evaluating potato resistance to black scurf caused by Rhizoctonia solani. Breed. Sci. 2014, 64, 156–163. [Google Scholar] [CrossRef]
- Harris, A.R.; Schisler, D.A.; Neate, S.M. Culture of Rhizoctonia solani and binucleate Rhizoctonia spp. on organic substrates for inoculation of seedlings in containers. Soil Biol. Biochem. 1993, 25, 337–341. [Google Scholar]
- Fery, R.L.; Dukes, P.D. Southern blight (Sclerotium rolfsii Sacc.) of cowpea: Yield-loss estimates and sources of resistance. Crop Prot. 2002, 21, 403–408. [Google Scholar] [CrossRef]
- Livak, K.J.; Schmittgen, T.D. Analysis of relative gene expression data using real-time quantitative PCR and the 2−ΔΔCT Method. Methods 2001, 25, 402–408. [Google Scholar] [CrossRef] [PubMed]
- Chandrasekaran, M.; Chun, S.C. Expression of PR-protein genes and induction of defense-related enzymes by Bacillus subtilis CBR05 in tomato (Solanum lycopersicum) plants challenged with Erwinia carotovora subsp. carotovora. Biosci. Biotech. Biochem. 2016, 80, 2277–2283. [Google Scholar] [CrossRef]
- Song, Y.; Chen, D.; Lu, K.; Sun, Z.; Zeng, R. Enhanced tomato disease resistance primed by arbuscular mycorrhizal fungus. Front. Plant Sci. 2015, 6, 786. [Google Scholar] [CrossRef]
- Rotenberg, D.; Thompson, T.S.; German, T.L.; Willis, D.K. Methods for effective real-time RT-PCR analysis of virus-induced gene silencing. J. Virol. Methods 2006, 138, 49–59. [Google Scholar] [CrossRef]
- Verhage, A.; van Wees, S.C.M.; Pieterse, C.M.J. Plant immunity: It’s the hormones talking, but what do they say? Plant Physiol. 2010, 154, 536–540. [Google Scholar] [CrossRef] [PubMed]
- Morcillo, R.J.; Singh, S.K.; He, D.; An, G.; Vílchez, J.I.; Tang, K.; Yuan, F.; Sun, Y.; Shao, C.; Zhang, S.; et al. Rhizobacterium-derived diacetyl modulates plant immunity in a phosphate-dependent manner. Embo J. 2020, 39, e102602. [Google Scholar] [CrossRef]
- Niu, D.D.; Liu, H.X.; Jiang, C.H.; Wang, Y.P.; Wang, Q.Y.; Jin, H.L.; Guo, J.H. The plant growth-promoting rhizobacterium Bacillus cereus AR156 induces systemic resistance in Arabidopsis thaliana by simultaneously activating salicylate- and jasmonate/ethylene-dependent signaling pathways. Mol. Plant Microbe Interact. 2011, 24, 533–542. [Google Scholar] [CrossRef] [PubMed]
- Kim, D.S.; Hwang, B.K. An important role of the pepper phenylalanine ammonia-lyase gene (PAL1) in salicylic acid-dependent signalling of the defence response to microbial pathogens. J. Exp. Bot. 2014, 65, 2295–2306. [Google Scholar] [CrossRef] [PubMed]
- Dixon, R.A.; Achnine, L.; Kota, P.; Liu, C.J.; Reddy, M.S.S.; Wang, L. The phenylpropanoid pathway and plant defence-a genomics perspective. Mol. Plant Pathol. 2002, 3, 371–390. [Google Scholar] [CrossRef]
- La Camera, S.; Gouzerh, G.; Dhondt, S.; Hoffmann, L.; Fritig, B.; Legrand, M.; Heitz, T. Metabolic reprogramming in plant innate immunity: The contributions of phenylpropanoid and oxylipin pathways. Immunol. Rev. 2004, 198, 267–284. [Google Scholar] [CrossRef]
- Feussner, I.; Wasternack, C. The lipoxygenase pathway. Annu. Rev. Plant Biol. 2002, 53, 275–297. [Google Scholar] [CrossRef] [PubMed]
- Bannenberg, G.; Martínez, M.; Hamberg, M.; Castresana, C. Diversity of the enzymatic activity in the lipoxygenase gene family of Arabidopsis thaliana. Lipids 2009, 44, 85–95. [Google Scholar] [CrossRef] [PubMed]
- Vatsa-Portugal, P.; Aziz, A.; Rondeau, M.; Villaume, S.; Morjani, H.; Clément, C.; Ait Barka, E. How Streptomyces anulatus primes grapevine defenses to cope with gray mold: A study of the early responses of cell suspensions. Front. Plant Sci. 2017, 8, 1043. [Google Scholar] [CrossRef] [PubMed]
- Gruau, C.; Trotel-Aziz, P.; Villaume, S.; Rabenoelina, F.; Clément, C.; Baillieul, F.; Aziz, A. Pseudomonas fluorescens PTA-CT2 triggers local and systemic immune response against Botrytis cinerea in grapevine. Mol. Plant Microbe Interact. 2015, 28, 1117–1129. [Google Scholar] [CrossRef] [PubMed]
- Miotto-Vilanova, L.; Jacquard, C.; Courteaux, B.; Wortham, L.; Michel, J.; Clément, C.; Barka, E.A.; Sanchez, L. Burkholderia phytofirmans PsJN confers grapevine resistance against Botrytis cinerea via a direct antimicrobial effect combined with a better resource mobilization. Front. Plant Sci. 2016, 7, 1236. [Google Scholar] [CrossRef] [PubMed]
- Goellner, K.; Conrath, U. Priming: It’s all the world to induced disease resistance. Eur. J. Plant Pathol. 2008, 121, 233–242. [Google Scholar] [CrossRef]
- Conn, V.M.; Walker, A.R.; Franco, C.M. Endophytic actinobacteria induce defense pathways in Arabidopsis thaliana. Mol. Plant Microbe Interact. 2008, 21, 208–218. [Google Scholar] [CrossRef] [PubMed]
- Passari, A.K.; Chandra, P.; Zothanpuia; Mishra, V.K.; Leo, V.V.; Gupta, V.K.; Kumar, B.; Singh, B.P. Detection of biosynthetic gene and phytohormone production by endophytic actinobacteria associated with Solanum lycopersicum and their plant-growth-promoting effect. Res. Microbiol. 2016, 167, 692–705. [Google Scholar] [CrossRef]
- Goudjal, Y.; Toumatia, O.; Sabaou, N.; Barakate, M.; Mathieu, F.; Zitouni, A. Endophytic actinomycetes from spontaneous plants of Algerian Sahara: Indole-3-acetic acid production and tomato plants growth promoting activity. World J. Microb. Biot. 2013, 29, 1821–1829. [Google Scholar] [CrossRef]
- Suárez-Moreno, Z.R.; Vinchira-Villarraga, D.M.; Vergara-Morales, D.I.; Castellanos, L.; Ramos, F.A.; Guarnaccia, C.; Degrassi, G.; Venturi, V.; Moreno-Sarmiento, N. Plant-growth promotion and biocontrol properties of three Streptomyces spp. isolates to control bacterial rice pathogens. Front. Microbiol. 2019, 10, 290. [Google Scholar] [CrossRef]
- Höfte, M.; Bakker, P. Competition for iron and induced systemic resistance by siderophores of plant growth promoting rhizobacteria. In Soil Biology, Microbial Siderophores; Varma, A., Chincholkar, S.B., Eds.; Springer: Berlin/Heidelberg, Germany, 2007; pp. 121–133. [Google Scholar]
- Aznar, A.; Dellagi, A. New insights into the role of siderophores as triggers of plant immunity: What can we learn from animals? J. Exp. Bot. 2015, 66, 3001–3010. [Google Scholar] [CrossRef]
- Buysens, S.; Heungens, K.; Poppe, J.; Hofte, M. Involvement of pyochelin and pyoverdin in suppression of Pythium-induced damping-off of tomato by Pseudomonas aeruginosa 7NSK2. Appl. Environ. Microbiol. 1996, 62, 865–871. [Google Scholar] [CrossRef]
- De Vleesschauwer, D.; Djavaheri, M.; Bakker, P.A.H.M.; Höfte, M. Pseudomonas fluorescens WCS374r-induced systemic resistance in rice against Magnaporthe oryzae is based on pseudobactin-mediated priming for a salicylic acid-repressible multifaceted defense response. Plant Physiol. 2008, 148, 1996–2012. [Google Scholar] [CrossRef]
- Ran, L.X.; Loon, L.; Bakker, P. No role for bacterially produced salicylic acid in rhizobacterial induction of systemic resistance in Arabidopsis. Phytopathology 2005, 95, 1349–1355. [Google Scholar] [CrossRef] [PubMed][Green Version]

| Gene Name | Primer Sequences | Reference |
|---|---|---|
| PAL1 | F-TCGTTATGCTCTCCGAACATCT R-ATTCACTGAGTTAATCTCCCTCTC | Chandrasekaran and Chun [59] |
| LOXB | F-ATCTCCCAAGTGAAACACCACA R-TCATAAACCCTGTCCCATTCTTC | Song et al. [60] |
| EF-1 α | F- GATTGGTGGTATTGGAACTGTC R- GCTTCGTGGTGCATCTCA | Rotenberg et al. [61] |
| Assay | Selected Actinomycetes Isolates | |||
|---|---|---|---|---|
| R7 | F8 | BH4-1 | BH4-3 | |
| Amylase | + | _ | + | + |
| Chitinase | _ | _ | + | + |
| Protease | + | + | + | + |
| Growth in EOPM * | + | + | + | + |
| HCN † Production | _ | _ | _ | _ |
| VOCs ‡ Production | _ | _ | _ | _ |
| Treatment | Root Length (cm) | Shoot Length (cm) | Seedlings Dry Weight (g) | Disease Severity |
|---|---|---|---|---|
| R7 † | 27.75 a | 44.25 b | 3.50 a | 1.0 e |
| R7 + P | 23.25 b | 45.00 a | 3.00 b | 2.0 d |
| BH4-3 ‡ | 22.50 c | 29.00 h | 2.75 c | 1.0 e |
| BH4-3 + P | 9.25 g | 21.75 j | 1.50 g | 2.4 b |
| F8 † | 27.75 a | 43.00 d | 2.75 c | 1.0 e |
| F8 + P | 15.00 f | 43.50 c | 2.50 d | 2.2 c |
| BH4-1 ‡ | 21.00 d | 33.00 g | 2.75 c | 1.0 e |
| BH4-1 + P | 19.00 e | 40.75 f | 2.25 e | 2.4 b |
| Pathogen | 8.00 h | 28.50 i | 2.00 f | 4.2 a |
| Control | 22.50 c | 42.50 e | 2.50 d | 1.0 e |
| Treatment | Mean Length of Lesion (mm) | Mean Width of Lesion (mm) |
|---|---|---|
| Pathogen (P) | 20.00 a | 7.50 a |
| F8 + P | 6.50 b | 5.00 a,b |
| R7 + P | 7.50 b | 3.50 b |
Publisher’s Note: MDPI stays neutral with regard to jurisdictional claims in published maps and institutional affiliations. |
© 2021 by the authors. Licensee MDPI, Basel, Switzerland. This article is an open access article distributed under the terms and conditions of the Creative Commons Attribution (CC BY) license (https://creativecommons.org/licenses/by/4.0/).
Share and Cite
Ebrahimi-Zarandi, M.; Bonjar, G.H.S.; Riseh, R.S.; El-Shetehy, M.; Saadoun, I.; Barka, E.A. Exploring Two Streptomyces Species to Control Rhizoctonia solani in Tomato. Agronomy 2021, 11, 1384. https://doi.org/10.3390/agronomy11071384
Ebrahimi-Zarandi M, Bonjar GHS, Riseh RS, El-Shetehy M, Saadoun I, Barka EA. Exploring Two Streptomyces Species to Control Rhizoctonia solani in Tomato. Agronomy. 2021; 11(7):1384. https://doi.org/10.3390/agronomy11071384
Chicago/Turabian StyleEbrahimi-Zarandi, Marzieh, Gholam Hosein Shahidi Bonjar, Roohallah Saberi Riseh, Mohamed El-Shetehy, Ismail Saadoun, and Essaid Ait Barka. 2021. "Exploring Two Streptomyces Species to Control Rhizoctonia solani in Tomato" Agronomy 11, no. 7: 1384. https://doi.org/10.3390/agronomy11071384
APA StyleEbrahimi-Zarandi, M., Bonjar, G. H. S., Riseh, R. S., El-Shetehy, M., Saadoun, I., & Barka, E. A. (2021). Exploring Two Streptomyces Species to Control Rhizoctonia solani in Tomato. Agronomy, 11(7), 1384. https://doi.org/10.3390/agronomy11071384

